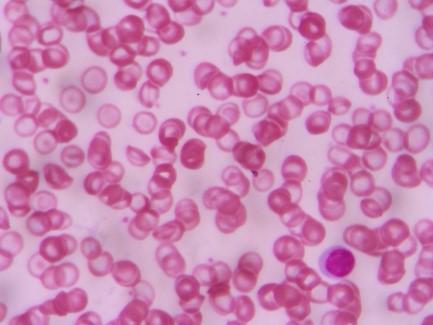
Anemia falciforme

Anemia ferropénica
Peer reviewed by Dr Colin Tidy, MRCGPLast updated by Dr Rachel Hudson, MRCGPLast updated 26 Apr 2023
Satisface las necesidades del paciente directrices editoriales
- DescargarDescargar
- Compartir
- Idioma
- Debate
In this series:AnaemiaDiets suitable for people with anaemiaFolic acid deficiencyMacrocytosis and macrocytic anaemiaVitamin B12 deficiency and pernicious anaemia
Iron-deficiency anaemia is a common type of anaemia that is caused by a lack of iron. Symptoms include pale skin and lack of energy. A low level of iron, leading to anaemia, can result from various causes. Some are more serious than others.
En este artículo:
Seguir leyendo
What is iron-deficiency anaemia?
Anaemia means:
You have fewer red blood cells than normal; or
You have less haemoglobin than normal in each red blood cell.
In either case, a reduced amount of oxygen is carried around in the bloodstream. The most common cause of anaemia in the UK is a lack of iron. Iron is needed to make haemoglobin. Anaemia caused by a lack of iron is called iron-deficiency anaemia (IDA).
Other types of anaemia (not related to iron deficiency) include:
What is iron and why do we need it?
Iron is a metal found widely in nature but it is also essential to a healthy body. It is used by the body to make haemoglobin, which carries oxygen around the body in red blood cells, and myoglobin which delivers oxygen to our muscles. It is also important for the healthy growth of hair, skin and nails. Experts are increasingly discovering how important iron is for the normal transmission of signals in the brain as well.
We get iron in our diet in two forms:
Haem iron, which is found in meat and fish.
Non-haem iron, which is found in vegetables and grains.
Symptoms of iron-deficiency anaemia
The symptoms of iron deficiency may be very vague, particularly if it isn't bad enough to have caused you to have developed iron-deficiency anaemia as well.
Some common symptoms of iron deficiency are:
Cansancio.
Struggling to concentrate at work or college.
Problemas de memoria.
Reducción de la capacidad para hacer ejercicio.
Pérdida de la condición del cabello y, posiblemente, caída del cabello.
Nails becoming brittle and breaking or splitting easily. They may even change shape, becoming concave or spoon-shaped, or may develop ridges.
Cuts and grazes taking a long time to heal.
A sore tongue.
Sores at the corners of your mouth.
Infants with iron deficiency may not develop as quickly as normal.
Pica syndrome: the craving or eating of substances not normally eaten, such as clay, chalk or coal.
Symptoms of anaemia:
Cansancio.
Shortness of breath, especially on exercise/exertion.
Palpitaciones.
Looking pale.
Feeling dizzy/faint.
Posibles complicaciones
Complications may develop if the iron deficiency becomes severe and is not treated. For example, you can develop fragile and broken nails, hair loss and heart failure. A lack of iron can also affect the immune system so you may become more likely to develop infections.
Anaemia in pregnancy increases the risk of complications in both mother and baby. For example, there is an increased risk of having a low-birth-weight baby, preterm (premature) delivery and postnatal depression. Low iron reserves in the baby may also lead to anaemia in the newborn baby.
Seguir leyendo
Causes of iron-deficiency anaemia
Iron deficiency is a common cause of anaemia, often seen in pregnancy. Low iron levels may be caused by bleeding - for example, heavy periods or from the gastrointestinal tract (gut) (stomach ulcer, bowel cancer or piles). Sometimes the gut can't absorb enough iron - for example, in coeliac disease. Iron is absorbed from the duodenum and jejunum part of the small intestine (the part after the stomach and before the large bowel/intestine.
A normal balanced diet will usually contain enough iron for your body's needs. A low level of iron, leading to anaemia, can result from various causes. Some are more serious than others, and include the following:
Heavy menstrual periods
Anaemia is common in women (of all ages) who have heavy periods. About 1 in 10 women will become anaemic at some point because of this. The amount of iron that you eat may not be enough to replace the iron that you lose during each period. Having heavy periods does not always lead to anaemia. Anaemia is more likely to develop if you have heavy periods and eat a diet that contains little iron.
Embarazo
A growing baby needs iron and will take it from the mother. Anaemia is common in pregnant women. It is more likely to develop during pregnancy if you eat a diet that has little iron.
Poor absorption of iron
Some conditions of the gut (intestine) lead to poor absorption of various foods, including iron. Coeliac disease is an example.
Bleeding from the gut
Several conditions of the gut can lead to bleeding. Sometimes this is sudden - for example, after a burst duodenal ulcer. Being sick (vomiting) or passing blood is obvious then.
Sometimes the bleeding is not obvious. A constant trickle of blood into the gut can be passed unnoticed in the stools (faeces). The iron that you may lose with the bleeding may be more than you eat. Conditions causing this include:
Stomach or duodenal ulcers.
Inflammation of the large intestine (colitis).
Inflammation of the gullet (oesophagus).
Piles (haemorrhoids).
Other rarer bowel disorders.
If you have one of these problems, you may have other gut symptoms such as stomach pains, constipation, or diarrhoea. However, in the early stages of these conditions, you may not have any symptoms and anaemia may be the first thing that is noticed. For example, iron-deficiency anaemia in an older person may be the first indication that bowel cancer has developed.
Medicación
Some medicines can sometimes cause bleeding into the gut without causing symptoms. The most common example is aspirin. Other anti-inflammatory painkillers such as ibuprofen, naproxen and diclofenac may also have this side-effect in some people. (Anti-inflammatory tablets may cause bleeding by irritating the stomach lining which may then lead to bleeding.)
Bleeding from the kidney
A small but regular trickle of blood from various diseases of the kidney or bladder may not be noticed in the urine. However, enough may be lost to cause anaemia.
Factores dietéticos
Not eating foods with enough iron is sometimes the cause of iron-deficiency anaemia. This is uncommon in the UK, as iron is in meat, liver, green vegetables, flour, eggs and other foods. Some people who have a poor diet with just enough iron to get by, may slip into anaemia if other factors develop. For example, a barely adequate diet combined with a growth spurt in children, or with a pregnancy or with heavy periods may lead to anaemia.
A restricted diet such as a vegan or limited vegetarian dietsometimes does not contain enough iron.
Traditional diets in some parts of the world contain a high level of chemicals such as phytates and polyphenols. For example, certain types of flatbreads (such as chapatis) may contain a high level of phytates. Tea can contain a high level of polyphenols. These chemicals interfere with the way iron is absorbed from the gut. So, if you eat a lot of these foods, it can lead to iron deficiency. For example, iron-deficiency anaemia is common in parts of India where chapatis are a staple food.
Hookworm infection
This gut infection is the most common cause of iron-deficiency anaemia worldwide. It affects people living in (or visiting) certain tropical countries. Hookworm feeds off blood inside the gut.
Cuándo contactar con un médico
Many of the symptoms of iron deficiency are also the symptoms of the busy, and sometimes stressful, lives we live. Tiredness and struggling to focus at work, for example, are very common and not usually due to iron deficiency. They usually just get better on their own after a week or two.
If you have had one or more of the symptoms listed above, for more than a few weeks, you should arrange to see a doctor or nurse. You can then have investigations carried out, which will include looking to see if iron deficiency is causing your symptoms. If you are short of iron, it is important to get medical advice.
Seguir leyendo
How is iron-deficiency anaemia diagnosed?
A doctor will ask you about your lifestyle and medical history. If the reason is unclear, a blood test can confirm that you are anaemic. A test called the full blood count (FBC) is the main test. For this test, the blood sample is put into a machine which automatically:
Counts the number of red cells, white cells and platelets per ml of blood.
Mide el tamaño de los glóbulos rojos y calcula su tamaño medio.
Calcula la proporción de sangre compuesta por glóbulos rojos (el hematocrito).
Mide la cantidad de hemoglobina en los glóbulos rojos.
This test can determine if you are anaemic. It usually also gives a good idea of the cause of the anaemia. But there are so many different causes of anaemia, the FBC cannot always help your doctor to know what the problem is.
You may need another blood test to confirm that the cause of the anaemia is due to lack of iron. This blood test measures a protein called ferritin. The level of this protein usually reflects the total body iron stores. A low level usually indicates that you have a lack of iron. The test can be difficult to interpret if infection or inflammation is present, as levels of ferritin can be high then, even if you are lacking (deficient) in iron.
Otras pruebas
It is important to find the cause of the iron deficiency. The cause may be obvious in some people. For example, anaemia is common in pregnancy and in women with heavy periods. In these situations, if you are otherwise well and have no other symptoms then no further tests may be needed. However, further tests may be advised if the cause is not clear. Every case is different and your doctor will assess if you should have further tests.
Tests that may be advised include one or more of the following:
Tests to look into the gut (intestine) to see if there is any internal bleeding. These may be advised even if you do not have gut symptoms, especially in older people. The tests may include a gastroscopy (endoscopy) which looks into the stomach. Checking the back passage (rectum) and bowel may also be advised. This is commonly done by a colonoscopy or sigmoidoscopy. It is sometimes done by having a computerised tomography (CT) scan of your tummy (abdomen).
A specialised blood test may be taken if coeliac disease is suspected as the cause. Sometimes a small sample (biopsy) of the lining of the gut may also be taken to diagnose coeliac disease.
If you have recently been to the tropics, a stool (faeces) sample may be checked to rule out hookworm.
Other tests may be advised if the cause is still unclear.
Treatment for iron-deficiency anaemia
Iron tablets are usually prescribed to correct the anaemia. Your doctor may refer you to hospital to have iron given in a different way if your anaemia does not improve on tablets, or you find it difficult to take the tablets. Other treatments may also be advised, depending on the underlying cause. See the separate leaflet called Diets Suitable for People with Anaemia.
Iron tablets
Various iron tablets and liquid medicines are available. Your doctor will advise on one. The length of course will depend on how bad the anaemia is. A blood test after a few weeks will show if the treatment is working. Drinking orange juice when you take your iron tablets can increase the absorption of iron into your body.
When your blood level is back to normal, you should continue to take iron for at least three further months. This will build up the stores of iron in your body. Blood tests at regular intervals after that will ensure you do not become anaemic again.
Some people have side-effects when taking iron. These include feeling sick (nausea), an upset stomach, constipation, or diarrhoea. You should tell a doctor if side-effects are a problem. Don't stop the iron or the anaemia will not get better. Possible ways to reduce the problem of side-effects are:
Taking the iron tablets with meals. Food reduces the absorption of the iron and so you may need to take a longer course to correct the anaemia.
Taking a lower dose; but again a longer course will be needed to correct the anaemia.
Drinking plenty of fluids if constipation develops.
Iron tablets may make your stools (faeces) black. This is normal and nothing to worry about. However, it is sometimes confused with blood in the stools from internal bleeding, which can also make your stools black.
Remember: keep iron tablets away from children, who may think that they are sweets. An overdose of iron tablets can be very dangerous in children.
How to prevent iron deficiency
Iron deficiency may be difficult to prevent if it is due to disease - for example, bleeding from the bowels. However, it should be possible to prevent iron deficiency that is due solely to not having enough iron in your diet. See the section below on iron-rich foods.
With increasing evidence that we need to limit our intake of meat, particularly red meat, how much iron do we need in our diet? The UK recommended daily intake for an adult man is 8.7 mg. For a woman who has not reached her menopause, this is increased to 14.8 mg. Higher amounts are needed in pregnancy and in children and young people.
How to help your body to absorb the iron in your diet
Vitamin C (also called ascorbic acid) helps the body to absorb non-haem iron from the gut.
Vitamin C is found in high amounts in:
Limones.
Limas.
Tomates.
Red peppers.
It is partially destroyed by cooking, so these foods will help more if you eat (or drink) them raw with your meal.
Lactic acid-fermented vegetables may also aid the absorption of non-haem iron. Sauerkraut and kimchi are examples of lacto-fermented vegetables.
Calcium, which is present in milk, yoghurt and cheese, interferes with the absorption of both haem iron and non-haem iron. So drinking cow's milk is best avoided during mealtimes. However, research has suggested that lactobacillus, such as is used in the production of live yoghurt, may aid in the absorption of non-haem iron.
Tea and coffee are best avoided at mealtimes too. This is because they contain chemicals called phenols which interfere with the absorption of non-haem iron.
Selección de pacientes para Anemia
Alergias, sangre y sistema inmunitario
Anemia falciforme
La anemia falciforme (ECF) es una enfermedad hereditaria grave que afecta a la sangre y a diversos órganos del cuerpo. Afecta a los glóbulos rojos y provoca episodios de "drepanocitosis", que producen dolor y otros síntomas. Entre los episodios de drepanocitosis, las personas con ECF suelen encontrarse bien. Pueden producirse complicaciones a largo plazo. Un buen tratamiento, iniciado en una fase temprana de la vida, puede prevenir las complicaciones. Por eso se recomienda un diagnóstico precoz y un tratamiento especializado. El rasgo drepanocítico no es lo mismo que la enfermedad de células falciformes.
por la Dra. Hayley Willacy, FRCGP

Alergias, sangre y sistema inmunitario
Anemia
Anemia significa tener menos glóbulos rojos de lo normal o menos hemoglobina de lo normal en cada glóbulo rojo. En ambos casos, la cantidad de oxígeno que circula por el torrente sanguíneo es menor.
por la Dra. Hayley Willacy, FRCGP
Lecturas complementarias y referencias
- Erythropoiesis-stimulating agents in the treatment of anaemia in cancer patients: ESMO Clinical Practice Guidelines for use; European Society for Medical Oncology (2010)
- Informe del Comité científico consultivo de la alimentación, el hierro y la saludGOV.UK, febrero de 2011
- Pereira DI, Bruggraber SF, Faria N, et al; Nanoparticulate iron(III) oxo-hydroxide delivers safe iron that is well absorbed and utilised in humans. Nanomedicine. 2014 Nov;10(8):1877-86. doi: 10.1016/j.nano.2014.06.012. Epub 2014 Jun 28.
- Jackson J, Williams R, McEvoy M, et al; Is Higher Consumption of Animal Flesh Foods Associated with Better Iron Status among Adults in Developed Countries? A Systematic Review. Nutrients. 2016 Feb 16;8(2):89. doi: 10.3390/nu8020089.
- Wheal MS, DeCourcy-Ireland E, Bogard JR, et al; Measurement of haem and total iron in fish, shrimp and prawn using ICP-MS: Implications for dietary iron intake calculations. Food Chem. 2016 Jun 15;201:222-9. doi: 10.1016/j.foodchem.2016.01.080. Epub 2016 Jan 21.
- Hoppe M, Onning G, Berggren A, et al; Probiotic strain Lactobacillus plantarum 299v increases iron absorption from an iron-supplemented fruit drink: a double-isotope cross-over single-blind study in women of reproductive age. Br J Nutr. 2015 Oct 28;114(8):1195-202. doi: 10.1017/S000711451500241X.
- Iron Dietary Supplement Fact Sheet; Office of Dietary Supplements, National Institutes of Health
- Killick SB, Bown N, Cavenagh J, et al; Guidelines for the diagnosis and management of adult aplastic anaemia. Br J Haematol. 2016 Jan;172(2):187-207. doi: 10.1111/bjh.13853. Epub 2015 Nov 16.
- Pavord S, Myers B, Robinson S, et al; UK guidelines on the management of iron deficiency in pregnancy. Br J Haematol. 2012 Mar;156(5):588-600.
- Nielsen OH, Soendergaard C, Vikner ME, et al; Rational Management of Iron-Deficiency Anaemia in Inflammatory Bowel Disease. Nutrients. 2018 Jan 13;10(1). pii: nu10010082. doi: 10.3390/nu10010082.
- Clinical Practice Guideline Anaemia of Chronic Kidney Disease; The Renal Association, 2017 - updated February 2020
- Anemia - carencia de hierroNICE CKS, agosto de 2024 (sólo acceso en el Reino Unido)
Seguir leyendo
Historia del artículo
La información de esta página ha sido redactada y revisada por médicos cualificados.
Fecha prevista para la próxima revisión: 14 mar 2028
26 Abr 2023 | Última versión

Pregunte, comparta, conecte.
Explore debates, formule preguntas y comparta experiencias sobre cientos de temas de salud.

¿Se encuentra mal?
Evalúe sus síntomas en línea de forma gratuita
Sign up to the Patient newsletter
Your weekly dose of clear, trustworthy health advice - written to help you feel informed, confident and in control.
By subscribing you accept our Privacy Policy. You can unsubscribe at any time. We never sell your data.